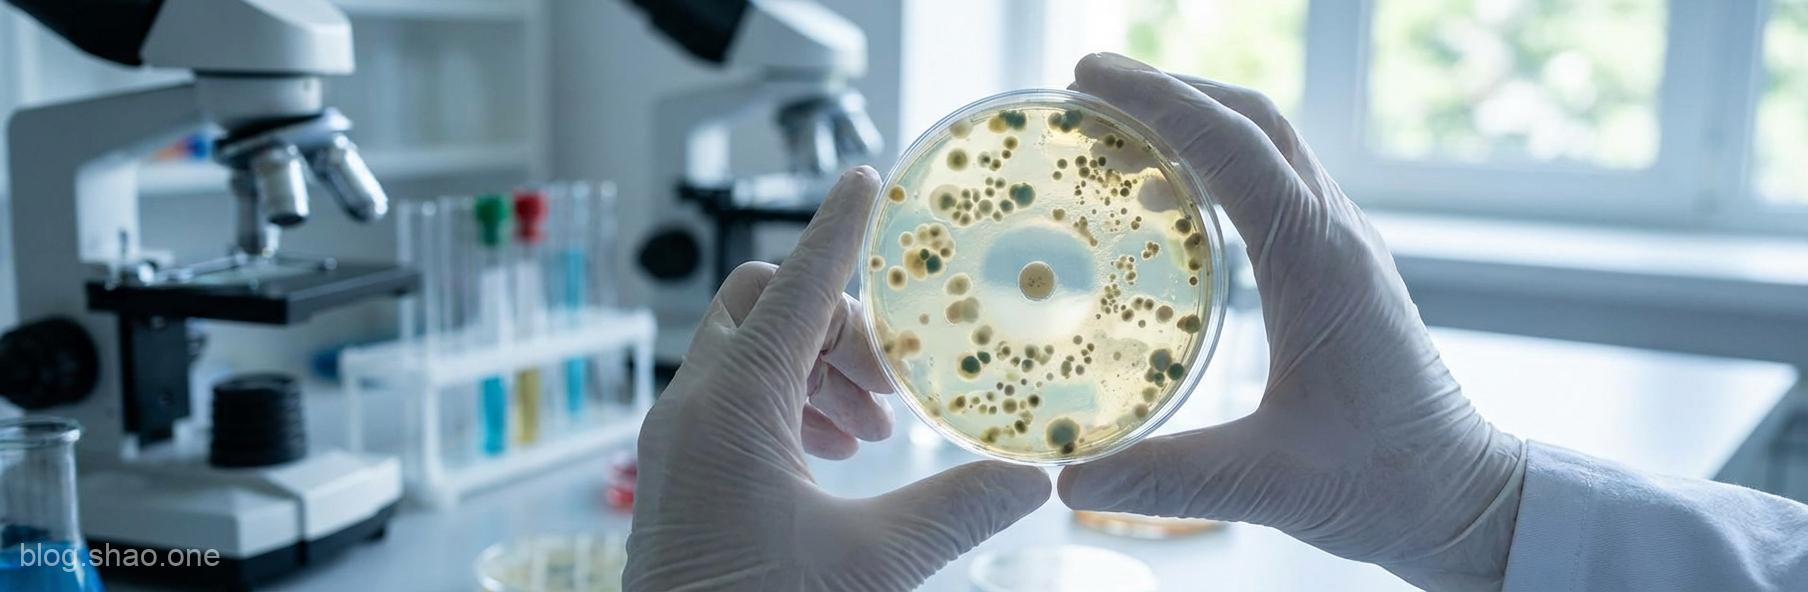
1766216773641

【科技新知】腸道戰場的新契機:別再讓抗生素「傷敵一千,自損八百」
在現代醫學的領域中,抗生素的發現無疑是讓人類從傳染病的威脅中脫胎換骨的里程碑。然而,長期以來,我們面臨著一個棘手的難題:傳統抗生素往往採取「地毯式轟炸」的策略,在消滅有害病菌的同時,也連帶誤傷了腸道內維持健康的益生菌群。這種寧可錯殺一百,不可放過一個的做法,往往導致患者腸道微生態失衡,進而引發嚴重的後遺症。
最近,來自荷蘭萊頓大學(Leiden University)的研究團隊傳來了令人振奮的捷報。他們開發出一種名為 EVG7 的新型「超級抗生素」,標榜能對症下藥,在不破壞腸道微生態的前提下,精準擊殺致命的「艱難梭菌」(C. difficile)。這項突破性的進展,無疑為腸道醫療科技注射了一劑強心針。
什麼是艱難梭菌?一場揮之不去的惡夢
艱難梭菌(Clostridioides difficile)是目前全球醫院內感染最常見的病原體之一。它最狡猾的地方在於,當患者服用廣效性抗生素治療其他疾病時,腸道內的益生菌會被大量殺滅,這時艱難梭菌便會乘虛而入,在空曠的腸道內大量繁殖並產生毒素,導致嚴重的腹瀉、結腸炎,甚至危及生命。
更令醫護人員頭痛的是,艱難梭菌極其頑強,復發率極高。許多患者在康復後,病菌又會死灰復燃。傳統療法往往陷入「用藥、殺菌、微生態失衡、再感染」的惡性循環。如何找到一種能釜底抽薪的治療方案,一直是生物醫療科技領域的當務之急。
EVG7:如同「精準狙擊手」般的超級抗生素
與傳統抗生素相比,EVG7 的出現可謂是別出心裁。萊頓大學的研究團隊表示,這種新型抗生素具備以下幾項令人驚豔的特性:
- 精準擊殺,不傷無辜:EVG7 展現了極高的選擇性。它就像是一名配置了高科技瞄準鏡的「狙擊手」,能精確鎖定艱難梭菌,而對腸道內的有益菌群(如擬桿菌門)保持友善。這意味著患者在治療期間,腸道「原住民」能安然無恙。
- 低劑量、高效率:實驗數據顯示,EVG7 在極低的劑量下即可發揮強大的殺菌效果。這種以小博大的特性,能顯著降低藥物副作用。
- 降低復發風險:由於腸道微生態在治療過程中得到了完整保留,身體天然的屏障依然穩固,這讓艱難梭菌難以再次興風作浪,大幅降低了病情的復發機率。
科技點評:為什麼這項發現具備劃時代意義?
在過去,開發新型抗生素的進展緩慢,導致人類在面對超強細菌時顯得束手無策。EVG7 的成功研發,不僅僅是多了一種藥物,更代表了抗生素研發邏輯的轉型——從「全面戰爭」轉向「精準制導」。
這對於精準醫療(Precision Medicine)的推動具有重大意義:
1. 微生物組保護:醫學界越來越意識到「腸道是第二大腦」,保護微生態就是保護免疫力。EVG7 證明了我們可以只除掉「壞人」而留住「好人」。
2. 抗藥性挑戰的轉機:針對特定路徑開發的抗生素,能減少細菌產生廣泛抗藥性的機會,讓其他抗生素不至於望塵莫及。
結語:長治久安的健康藍圖
雖然 EVG7 目前仍處於研究與開發階段,距離正式臨床普及還有一段路要走,但這項成果已足以讓我們對未來充滿期待。萊頓大學團隊的鍥而不捨,為無數深受腸道感染之苦的患者點燃了希望之火。
隨著這類新型「超級抗生素」的成熟,未來我們在面對細菌感染時,將不再需要付出「損害全身健康」的慘痛代價。一個更安全、更精準的醫療時代,已是指日可待。讓我們持續關注這項技術的後續發展,期待它能早日應用於臨床,為人類的腸道健康保駕護航!